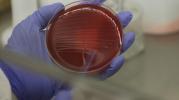

Le cellule cerebrali create in laboratorio generano grovigli di proteine tipici della patologia
Un gruppo di scienziati, guidati da Rudolph E. Tanzi, del Massachusetts General Hospital di Boston è riuscito a creare per la prima volta un modello della malattia di Alzheimer: ovvero una capsula di Petri con cellule del cervello umano che sono state indotte a sviluppare questa grave patologia.
Le cellule cerebrali create in laboratorio generano grovigli di proteine tipici della patologia
Un gruppo di scienziati, guidati da Rudolph E. Tanzi, del Massachusetts General Hospital di Boston è riuscito a creare per la prima volta un modello della malattia di Alzheimer: ovvero una capsula di Petri con cellule del cervello umano che sono state indotte a sviluppare questa grave patologia.Leggi tutto...
 Nonostante alcuni sintomi siano inconfondibili, nella maggior parte dei casi l’osteoporosi risulta asintomatica. Ecco perché è importante sottoporsi a controlli preventivi a partire dai 30 anni
Sono oltre 200 milioni le persone nel mondo affette da osteoporosi, ma nonostante ciò questa condizione molto spesso non viene riconosciuta o non si riesce a diagnosticarla a causa della sua asintomaticità. La maggior parte delle persone infatti, scopre di essere...
Nonostante alcuni sintomi siano inconfondibili, nella maggior parte dei casi l’osteoporosi risulta asintomatica. Ecco perché è importante sottoporsi a controlli preventivi a partire dai 30 anni
Sono oltre 200 milioni le persone nel mondo affette da osteoporosi, ma nonostante ciò questa condizione molto spesso non viene riconosciuta o non si riesce a diagnosticarla a causa della sua asintomaticità. La maggior parte delle persone infatti, scopre di essere...Leggi tutto...
 Il massaggio può essere un grande aiuto quando aggiunto ad un regime di trattamento della spondilite anchilosante
Se siete alla ricerca di sollievo dal dolore della spondilite anchilosante, un massaggio non allevierà solo i muscoli irrigiditi, ma contribuirà a ridurre l'infiammazione collegata.
Il massaggio può essere un grande aiuto quando aggiunto ad un regime di trattamento della spondilite anchilosante
Se siete alla ricerca di sollievo dal dolore della spondilite anchilosante, un massaggio non allevierà solo i muscoli irrigiditi, ma contribuirà a ridurre l'infiammazione collegata.Leggi tutto...
Una birra un paio di volte alla settimana, aiuterebbe le donne ad evitare l'artrite reumatoide dolorosa, come suggerito da un nuovo studio
L’artrite reumatoide è una malattia che colpisce le donne più degli uomini ed è una forma di artrite legata a disfunzioni del sistema immunitario.
Una birra un paio di volte alla settimana, aiuterebbe le donne ad evitare l'artrite reumatoide dolorosa, come suggerito da un nuovo studio
L’artrite reumatoide è una malattia che colpisce le donne più degli uomini ed è una forma di artrite legata a disfunzioni del sistema immunitario.Leggi tutto...
Stare in forma
Donne che si trascurano troppo
Donne che non riescono a stare in forma, ma non in senso estetico: magari trovano il tempo per truccarsi e comprarsi l'ennesimo vestito, ma non si alimentano con criterio e sono preda di una serie di cattive abitudini lontane anni luce da vita sana, relax e benessere.
Donne che non cucinano, preferendo cibi precotti, pranzi al ristorante e digiuni per dimagrire.
Contro il colesterolo cattivo
Contro il colesterolo cattivo
Il colesterolo è necessariamente cattivo? Niente affatto. Anzi, il colesterolo è un lipide necessario per la vita (compone la membrana cellulare, stabilizza le cellule ed ha un ruolo chiave nella formazione degli ormoni - es. estrogeni e
testosterone -). Questo lipide può essere trasportato
da lipoproteine a bassa (LDL) o ad alta densità (HDL). Il primo tipo (LDL) è il cosiddetto colesterolo "cattivo", perché può ostruire le
arterie, il secondo (HDL) è addirittura benefico ed ha un effetto pulente.
Capelli secchi e sfibrati
Phon, tinture e piastra lisciante possono rendere i capelli secchi e sfibrati. Ecco alcuni rimedi.
Le nuove tendenze impongono capelli sempre in ordine, frange perfette, liscio assoluto o onde morbide e setose. Chi ha i capelli crespi o ricci, oltre a ricorrere spesso a tinture e prodotti chimici, si trova costretto ad usare la piastra lisciante. Il capello, in particolar modo se già colorato, si secca ulteriormente, diventa debole, perde luminosità ed acquista un aspetto poroso, che lo espone ancor di più all'effetto umidità e al rischio di rottura e caduta.
Ipertensione in gravidanza
Come combattere l'ipertensione nei primi nove mesi?
L'alimentazione è come sempre un primo rimedio di prevenzione primaria al quale ricorrere per scongiurare problemi di ipertensione arteriosa e altre conseguenze, soprattutto nei primi mesi di gravidanza.
Ipotensione ortostatica
Cos'è l'ipotensione ortostatica e come si manifesta?
L’ipotensione ortostatica è una patologia cardiocircolatoria. Per ipotensione ortostatica si intende l’impossibilità di mantenere la stazione eretta a causa di un calo eccessivo della pressione del sangue quando il soggetto passa dalla posizione coricata (clinostatica) alla posizione in piedi (ortostatica).
Farmaci e obesità
Farmaci nell'obesità: una guida per conoscerli e saperli usare
I farmaci, come è noto, hanno delle proprietà curative mirate, a seconda dell’uso che se ne fa, a correggere o a modificare delle funzioni fisiologiche, esercitando azioni farmacologiche, immunologiche o metaboliche. Tuttavia nell’assunzione di un farmaco specifico per la cura di una malattia o disfunzione è sempre bene conoscerne nel dettaglio le caratteristiche, la posologia e l’impatto sul nostro organismo che varia di persona in persona. I farmaci possono comportare anche degli effetti collaterali indesiderati, per questo è buona norma consultare periodicamente il medico che ne ha prescritto l’uso e che può garantirne l’efficacia e la migliore gestione anche in concomitanza con fattori indipendenti dall’uso specifico del farmaco.Di seguito riportiamo le descrizioni di alcuni farmaci destinati alla cura dell'obesità.
1 . 2 . 3 . 4 . 5 . 6 . 7 . 8 . 9 . 10 . 11 . 12 . 13 . 14 . 15 . 16 . 17 . 18 . 19 .







